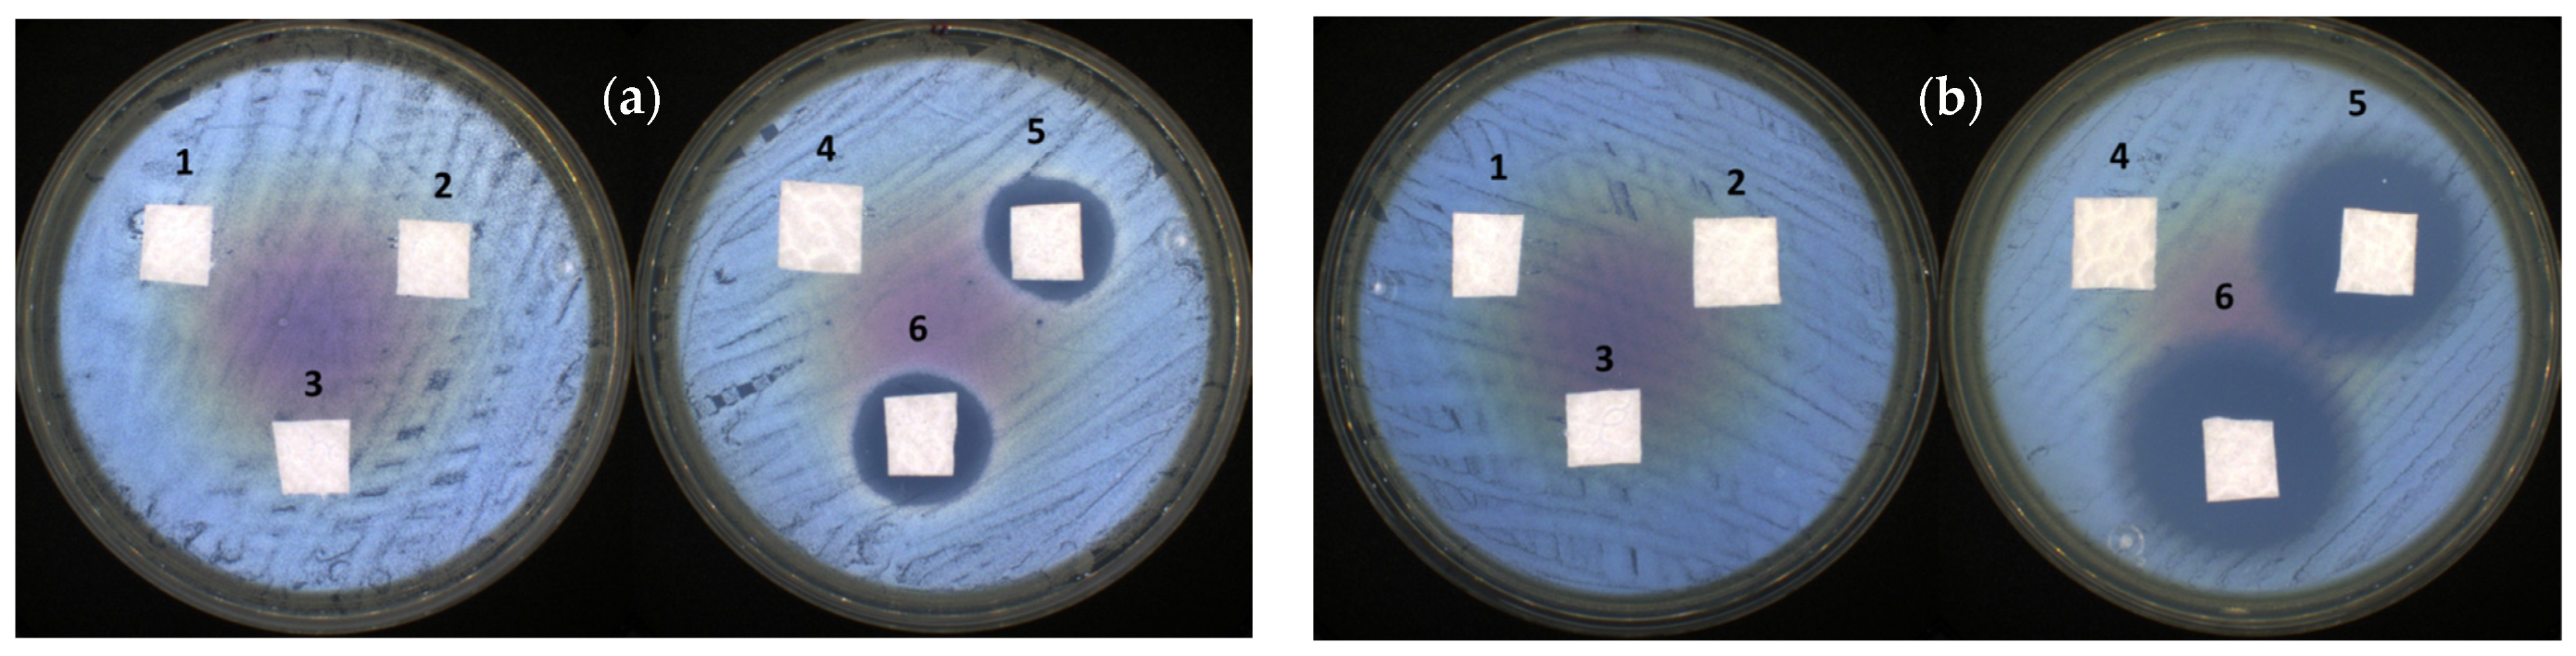
Nanomaterials 14 00197 g011

Zein/Polysaccharide Nanoscale Electrostatic Complexes: Preparation, Drug Encapsulation and Antibacterial Properties
Abstract
1. Introduction
2. Materials and Methods
2.1. Materials
2.2. Solution Characterization
2.3. Synthesis of the NPEC Nanoparticles
2.4. NPEC Nanoparticle Interaction with Ciprofloxacin
2.5. NPEC and NPEC/CF Deposition on Nonwoven Cellulosic Material
2.6. Characterization Methods
2.7. Antibacterial Activity
3. Results and Discussion
3.1. Zein Characterization in Solution as a Function of the Alcohol Content and pH
3.2. Characterization of the NPECs
3.3. NPEC/Ciprofloxacin Composite Particles
3.4. Antibacterial Properties of the CF/NPEC Particles
4. Conclusions
Supplementary Materials
Author Contributions
Funding
Data Availability Statement
Conflicts of Interest
References
- Chauhan, D.S.; Arunkumar, P.; Prasad, R.; Mishra, S.K.; Reddy, B.P.K.; De, A.; Srivastava, R. Facile synthesis of plasmonic zein nanoshells for imaging-guided photothermal cancer therapy. Mater. Sci. Eng. C 2018, 90, 539–548. [Google Scholar] [CrossRef] [PubMed]
- Cheng, H.; Hsieh, S.; Chen, T.; Hung, P.; Pan, S. Sorafenib-fortified zein-chondroitin sulphate biopolymer nanoparticles as a novel therapeutic system in gastric cancer treatment. RSC Adv. 2016, 6, 57266–57274. [Google Scholar] [CrossRef]
- Chen, X.; Chen, Y.; Zou, L.; Zhang, X.; Dong, Y.; Tang, J.; McClements, D.J.; Liu, W. Plant-based nanoparticles prepared from proteins and phospholipids consisting of a core–multilayer-shell structure: Fabrication, stability, and foamability. J. Agric. Food Chem. 2019, 67, 6574–6584. [Google Scholar] [CrossRef] [PubMed]
- Li, F.; Qiu, C.; Li, M.; Xiong, L.; Shi, Y.; Sun, Q. Preparation and characterization of redox-sensitive glutenin nanoparticles. Int. J. Biol. Macromol. 2019, 137, 327–336. [Google Scholar] [CrossRef]
- Wang, S.; Lu, Y.; Quyang, X.-K.; Ling, J. Fabrication of soy protein isolate/cellulose nanocrystal composite nanoparticles for curcumin delivery. Int. J. Biol. Macromol. 2020, 165, 1468–1474. [Google Scholar] [CrossRef] [PubMed]
- Reddy, N.; Rapisarda, M. Properties and applications of nanoparticles from plant proteins. Materials 2021, 14, 3607. [Google Scholar] [CrossRef] [PubMed]
- Li, M.; Yu, M. Development of a nanoparticle delivery system based on zein/polysaccharide complexes. J. Food Sci. 2020, 85, 4108–4117. [Google Scholar] [CrossRef]
- Weissmueller, N.T.; Lu, H.D.; Hurley, A.; Prud’homme, R.K. Nanocarriers from GRAS Zein Proteins to Encapsulate Hydrophobic Actives. Biomacromolecules 2016, 17, 3828–3837. [Google Scholar] [CrossRef]
- Luo, Y.; Wang, Q. Zein-based micro- and nano-particles for drug and nutrient delivery: A review. J. Appl. Polym. Sci. 2014, 131, 40696. [Google Scholar] [CrossRef]
- Hu, K.; McClements, D.J. Fabrication of biopolymer nanoparticles by antisolvent precipitation and electrostatic deposition: Zein-alginate core/shell nanoparticles. Food Hydrocoll. 2015, 44, 101–108. [Google Scholar] [CrossRef]
- Ganguly, K.; Chaturvedi, K.; More, U.A.; Nadagouda, M.N.; Aminabhavi, T.M. Polysaccharide based micro/nanohydrogels for delivering macromolecular therapeutics. J. Control. Release 2014, 193, 162–173. [Google Scholar] [CrossRef] [PubMed]
- Evans, M.; Ratcliffe, I.; Williams, P.A. Emulsion stabilisation using polysaccharide–protein complexes. Curr. Opin. Colloid Interface Sci. 2013, 18, 272–282. [Google Scholar] [CrossRef]
- Gheorghita (Puscaselu), R.; Gutt, G.; Amariei, S. The use of edible films based on sodium alginate in meat product packaging: An eco-friendly alternative to conventional plastic materials. Coatings 2020, 10, 166. [Google Scholar] [CrossRef]
- Shan, P.; Wang, K.; Yu, F.; Yi, L.; Sun, L.; Li, H. Gelatin/sodium alginate multilayer composite film crosslinked with green tea extract for active food packaging application. Colloids Surf. A 2023, 662, 131013. [Google Scholar] [CrossRef]
- Wróblewska-Krepsztul, J.; Rydzkowski, T.; Michalska-Pożoga, I.; Thakur, V.K. Biopolymers for biomedical and pharmaceutical applications: Recent advances and overview of alginate electrospinning. Nanomaterials 2019, 9, 404. [Google Scholar] [CrossRef]
- Deepthi, S.; Jayakumar, R. Alginate nanobeads interspersed fibrin network as in situ forming hydrogel for soft tissue engineering. Bioact. Mater. 2018, 3, 194–200. [Google Scholar] [CrossRef] [PubMed]
- Al-Moalemi, H.A.; Razak, S.I.A.; Bohari, S.P.M. Electrospun sodium alginate/poly(ethylene oxide) nanofibers for wound healing applications: Challenges and future directions. Cellul. Chem. Technol. 2022, 56, 251–270. [Google Scholar] [CrossRef]
- Kim, H.W.; Kim, B.R.; Rhee, H. Imparting durable antimicrobial properties to cotton fabrics using alginate quaternary ammonium complex nanoparticles. Carbohydr. Polym. 2010, 79, 1057–1062. [Google Scholar] [CrossRef]
- Zhao, L.; Liu, M.; Wang, J.; Zhai, G. Chondroitin sulfate-based nanocarriers for drug/gene delivery. Carbohydr. Polym. 2015, 133, 391–399. [Google Scholar] [CrossRef]
- Moghadam, N.A.; Bagheri, F.; Eslaminejad, M.B. Chondroitin sulfate modified chitosan nanoparticles as an efficient and targeted gene delivery vehicle to chondrocytes. Colloids Surf. B 2022, 219, 112786. [Google Scholar] [CrossRef]
- Amhare, A.F.; Lei, J.; Deng, H.; Lv, Y.; Han, J.; Zhang, L. Biomedical application of chondroitin sulfate with nanoparticles in drug delivery systems: Systematic review. J. Drug Target. 2020, 29, 259–268. [Google Scholar] [CrossRef]
- Rodrigues, M.N.; Oliveira, M.B.; Costa, R.R.; Mano, J.F. Chitosan/Chondroitin sulfate membranes produced by polyelectrolyte complexation for cartilage engineering. Biomacromolecules 2016, 17, 2178–2188. [Google Scholar] [CrossRef] [PubMed]
- Sharma, R.; Kuche, K.; Thakor, P.; Bhavana, V.; Srivastava, S.; Mehra, N.K.; Jain, S. Chondroitin Sulfate: Emerging biomaterial for biopharmaceutical purpose and tissue engineering. Carbohydr. Polym. 2022, 286, 119305. [Google Scholar] [CrossRef]
- Yu, L.; Liu, X.; Yuan, W.; Brown, L.J.; Wang, D. Confined flocculation of ionic pollutants by poly(L-dopa)-based polyelectrolyte complexes in hydrogel beads for three-dimensional, quantitative, efficient water decontamination. Langmuir 2015, 31, 6351–6366. [Google Scholar] [CrossRef] [PubMed]
- Panova, I.G.; Sybachin, A.V.; Spiridonov, V.V.; Kydralieva, K.; Jorobekova, S.; Zezin, A.B.; Yaroslavov, A.A. Non-stoichiometric interpolyelectrolyte complexes: Promising candidates for protection of soils. Geoderma 2017, 307, 91–97. [Google Scholar] [CrossRef]
- Yan, X.; Khor, E.; Lim, L.-Y. PEC films prepared from chitosan-alginate coacervates. Chem. Pharm. Bull. 2000, 48, 941–946. [Google Scholar] [CrossRef]
- Jardim, K.V.; Siqueira, J.L.N.; Báo, S.N.; Sousa, M.H.; Parize, A.L. The role of the lecithin addition in the properties and cytotoxic activity of chitosan and chondroitin sulfate nanoparticles containing curcumin. Carbohydr. Polym. 2020, 227, 115351. [Google Scholar] [CrossRef]
- Mihai, M.; Dragan, E.S. Chitosan based nonstoichiometric polyelectrolyte complexes as specialized flocculants. Colloids Surf. A 2009, 346, 39–46. [Google Scholar] [CrossRef]
- Mihai, M.; Ghiorghiţă, C.A.; Stoica, I.; Niţă, L.; Popescu, I.; Fundueanu, G. New polyelectrolyte complex particles as colloidal dispersions based on weak synthetic and/or natural polyelectrolytes. eXPRESS Polym. Lett. 2011, 5, 506–515. [Google Scholar] [CrossRef]
- Dragan, E.S.; Mihai, M.; Schwarz, S. Complex nanoparticles based on chitosan and ionic/nonionic strong polyanions: Formation, stability, and application. ACS Appl. Mater. Interfaces 2009, 1, 1231–1240. [Google Scholar] [CrossRef]
- De Marco, I. Zein Microparticles and Nanoparticles as Drug Delivery Systems. Polymers 2022, 14, 2172. [Google Scholar] [CrossRef]
- Micsonai, A.; Wien, F.; Kernya, L.; Lee, Y.-H.; Goto, Y.; Réfrégiers, M.; Kardos, J. Accurate secondary structure prediction and fold recognition for circular dichroism spectroscopy. Proc. Natl. Acad. Sci. USA 2015, 112, E3095–E3103. [Google Scholar] [CrossRef]
- Micsonai, A.; Wien, F.; Bulyáki, É.; Kun, J.; Moussong, É.; Lee, Y.H.; Goto, Y.; Réfrégiers, M.; Kardos, J. BeStSel: A web server for accurate protein secondary structure prediction and fold recognition from the circular dichroism spectra. Nucleic Acids Res. 2018, 46, W315–W322. [Google Scholar] [CrossRef]
- Bauer, A.W.; Perry, D.M.; Kirby, W.M.M. Single disc antibiotic sensitivity testing of Staphylococci: An analysis of technique and results. AMA Arch. Intern. Med. 1959, 104, 208–216. [Google Scholar] [CrossRef]
- Clinical and Laboratory Standards Institute (CLSI). Performance Standards for Antimicrobial Susceptibility Testing, 32nd ed.; CLSI supplement M100; Clinical and Laboratory Standards Institute: Berwyn, PA, USA, 2022. [Google Scholar]
- Dong, S.; Wang, J.-M.; Cheng, L.-M.; Lu, Y.-L.; Li, S.-H.; Chen, Y. Behavior of zein in aqueous ethanol under atmospheric pressure cold plasma treatment. J. Agric. Food Chem. 2017, 65, 7352–7360. [Google Scholar] [CrossRef]
- Momany, F.A.; Sessa, D.J.; Lawton, J.W.; Selling, G.W.; Hamaker, S.A.H.; Willett, J.L. Structural characterization of α-zein. J. Agric. Food Chem. 2006, 54, 543–547. [Google Scholar] [CrossRef]
- Vasiliu, A.-L.; Zaharia, M.-M.; Bazarghideanu, M.-M.; Rosca, I.; Peptanariu, D.; Mihai, M. Hydrophobic composites designed by a nonwoven cellulose-based material and polymer/CaCO3 patterns with biomedical application. Biomacromolecules 2022, 23, 89–99. [Google Scholar] [CrossRef]
- Campoli-Richards, D.M.; Monk, J.P.; Price, A.; Benfield, P.; Todd, P.A.; Ward, A. Ciprofloxacin. A review of its antibacterial activity, pharmacokinetic properties and therapeutic use. Drugs 1988, 35, 373–447. [Google Scholar] [CrossRef] [PubMed]

| Sample Code | Titrant, 10−4 M (mL) | Titrate, 10−5 M (mL) | Charge Molar Ratio, n(+/−) or n(−/+) | Addition Rate, mL·min−1 |
|---|---|---|---|---|
| (Zxx/PZ)0.4 or (PZ/Zxx)0.4 | 1.2 | 30 | 0.4 | 0.03/0.08 |
| (Zxx/PZ)0.6 or (PZ/Zxx)0.6 | 1.8 | 0.6 | ||
| (Zxx/PZ)0.8 or (PZ/Zxx)0.8 | 2.4 | 0.8 | ||
| (Zxx/PZ)1.2 or (PZ/Zxx)1.2 | 3.6 | 1.2 | ||
| (Zxx/PZ)1.4 or (PZ/Zxx)1.4 | 4.2 | 1.4 | ||
| (Zxx/PZ)1.6 or (PZ/Zxx)1.6 | 4.8 | 1.6 | ||
| (Zxx/PZ)1.8 or (PZ/Zxx)1.8 | 5.4 | 1.8 |
| Sample No. | Sample Code | Inhibition Zone (mm) | |
|---|---|---|---|
| S. aureus | E. coli | ||
| 1 | NWM | - | - |
| 2 | NWM + Z70 10−4 M | - | - |
| 3 | NWM + (Z70/ALG)0.8 | - | - |
| 4 | NWM + (Z70/CSA)0.8 | - | - |
| 5 | NWM + CF/(Z70/ALG)0.8 = 9 | 21.35 ± 2.33 | 25.15 ± 1.20 |
| 6 | NWM + CF/(Z70/CSA)0.8 = 9 | 20.10 ± 0.57 | 27.75 ± 1.20 |
Disclaimer/Publisher’s Note: The statements, opinions and data contained in all publications are solely those of the individual author(s) and contributor(s) and not of MDPI and/or the editor(s). MDPI and/or the editor(s) disclaim responsibility for any injury to people or property resulting from any ideas, methods, instructions or products referred to in the content. |
© 2024 by the authors. Licensee MDPI, Basel, Switzerland. This article is an open access article distributed under the terms and conditions of the Creative Commons Attribution (CC BY) license (https://creativecommons.org/licenses/by/4.0/).
Share and Cite
Lotos, E.-D.; Mihai, M.; Vasiliu, A.-L.; Rosca, I.; Mija, A.; Simionescu, B.C.; Pispas, S. Zein/Polysaccharide Nanoscale Electrostatic Complexes: Preparation, Drug Encapsulation and Antibacterial Properties. Nanomaterials 2024, 14, 197. https://doi.org/10.3390/nano14020197
Lotos E-D, Mihai M, Vasiliu A-L, Rosca I, Mija A, Simionescu BC, Pispas S. Zein/Polysaccharide Nanoscale Electrostatic Complexes: Preparation, Drug Encapsulation and Antibacterial Properties. Nanomaterials. 2024; 14(2):197. https://doi.org/10.3390/nano14020197
Chicago/Turabian StyleLotos, Elena-Daniela, Marcela Mihai, Ana-Lavinia Vasiliu, Irina Rosca, Alice Mija, Bogdan C. Simionescu, and Stergios Pispas. 2024. "Zein/Polysaccharide Nanoscale Electrostatic Complexes: Preparation, Drug Encapsulation and Antibacterial Properties" Nanomaterials 14, no. 2: 197. https://doi.org/10.3390/nano14020197
APA StyleLotos, E.-D., Mihai, M., Vasiliu, A.-L., Rosca, I., Mija, A., Simionescu, B. C., & Pispas, S. (2024). Zein/Polysaccharide Nanoscale Electrostatic Complexes: Preparation, Drug Encapsulation and Antibacterial Properties. Nanomaterials, 14(2), 197. https://doi.org/10.3390/nano14020197











